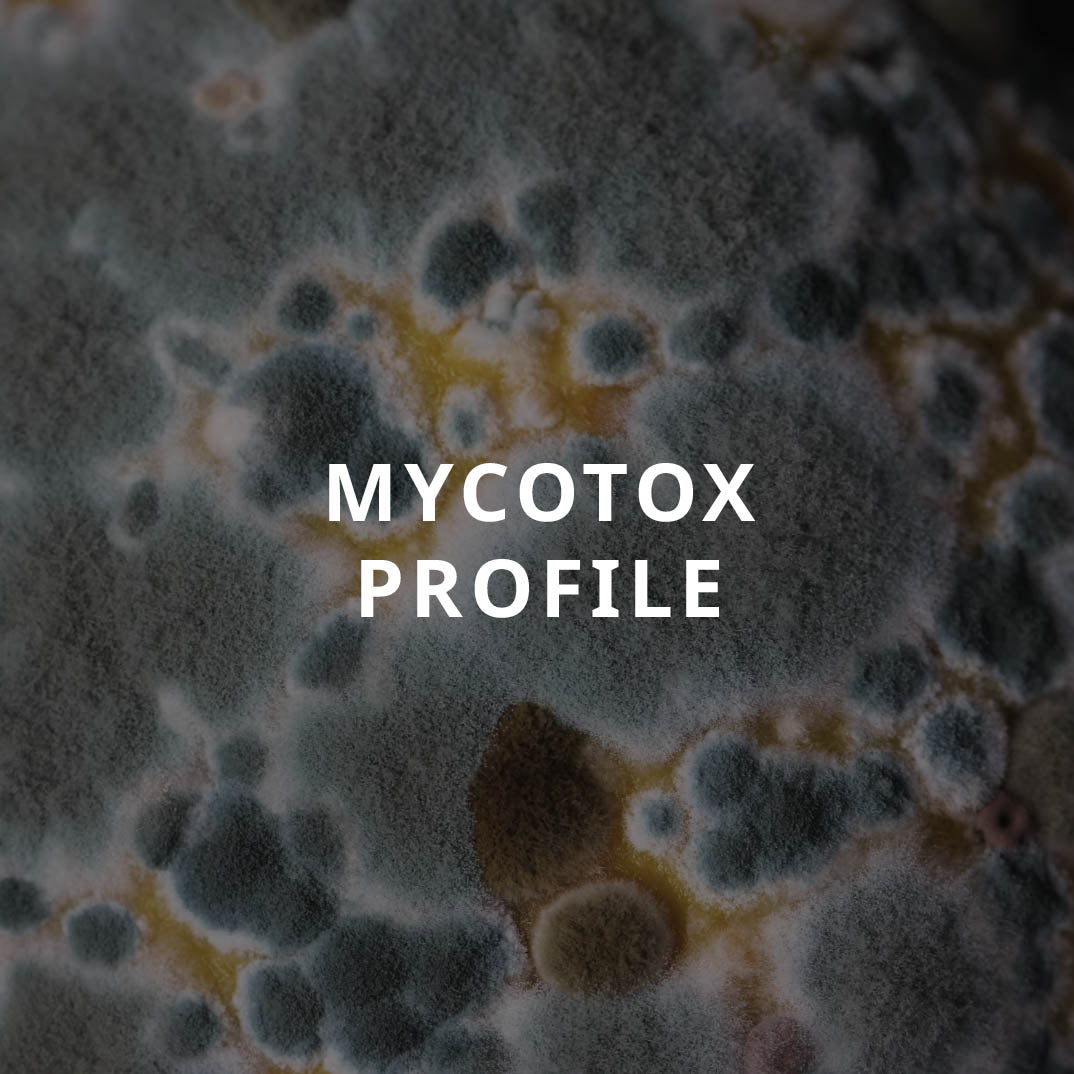

Lab Test Asia
Mycotox Profile
Mycotox Profile
Couldn't load pickup availability
Sample Type: Urine
This test assesses mold-related toxicity levels.
Mold organisms can be highly prevalent in tropical climates or water-damaged buildings. They release thousands of toxic compounds called mycotoxins into the air we breathe, leading to diverse symptoms such as allergies, skin rashes, asthma, headaches and brain fog.
If you frequently have similar symptoms or suspect you have been exposed to mold, this urine test is an easy way to understand more about your current exposure, helping to identify the level of exposure, how well you are eliminating the toxins, and which specific type of mold toxin is affecting your body. This helps inform how best to remove the sources of mould in your environment with the right products to reduce exposure.
What's included in the order
What's included in the order
- 15 minute virtual consultation with a functional test expert
- Free shipping of the test kit to your address
- Free return courier to submit your sample to the lab
- Detailed test result report delivered via email
What does the report contain?
What does the report contain?
Read our 5-star reviews
Customers across Asia Pacific trust Lab Test Asia for fast and reliable insights to improve their health. Read what they have to say on the world's leading independent site for reviews.